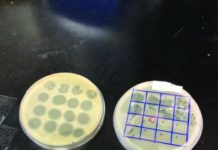
Chemical-free food safety – food in canada

DeSantis Administration Issues Proposed Ban on Medicaid Coverage for Transgender Treatments – FlaglerLive.com
Gov. Ron DeSantis’ administration moved forward Friday with a proposal that would deny Medicaid coverage for treatments such as puberty-blocking medication and hormone therapy for transgender people. The state Agency for...
How Science Tried, and Failed, to Find a “Gay Gene” – The Debrief
With the celebration of pride month in June, science is confronted with the hard reality of historic crimes against the LGBTQ+ community on an annual basis.
From inhumane treatment (among the...
A Great Science Fiction Writer Underwhelms With Climate Change Thriller – The Federalist
Not only is Neal Stephenson an influential writer, but he is also a prophet, perhaps the highest praise one can give to a science fiction writer. His novel “Snow Crash” conceptualized...
Deborah Birx Praises ‘Extraordinary’ LGBTQ Community for Preventing Monkeypox Spread – Newsweek
Dr. Deborah Birx has praised the LGBTQ community for helping prevent the spread of monkeypox. The physician and diplomat told Newsweek the community is "extraordinary responsible" that the American public can...
The Two Gentlemen Behind Napa’s Gentleman Farmer – Wine Spectator
Vintners Joe Wolosz and Jeff Durham founded Gentleman Farmer in 2005, making just 80 cases that vintage. Today they make about 1,000 cases of Napa Cabernet Sauvignon, Merlot and Chardonnay annually,...
A Word In Edgewise: Faster, Furiouser-–Whither? – Lavender Magazine
It was a different world, then. Of course, it always is. If I tell you mine was slower, calmer, a grand or great-grand will insist it was more so in their day, and...
Dorothy E. Smith, Groundbreaker in Feminist Sociology, Dies at 95 – The New York...
While she first applied her approach as a middle-class, educated, heterosexual mother and wrote about it in feminist terms, Dr. Smith saw it as a tool available to anyone marginalized by...
Newsroom | Anthony Fauci, MD, ’62 advises Holy Cross Students: Expect the Unexpected –...
<!-- --> Before the dedication ceremony of the Anthony S. Fauci Integrated Science Complex on June 11, the class of 1962 alumnus met with College of the Holy Cross students for...
Disney delays thousands of Florida jobs with DeSantis feud as backdrop – Tallahassee Democrat
Gov. Ron DeSantis’ office moved quickly Thursday to dismiss speculation that a simmering feud over controversial legislation has anything to do with the Walt Disney Co. delay in moving 2,000 high-paying jobs to...
UIS professor publishes book with a LGBTQ twist on sex discrimination case – NPR...
The University Press of Kansas published in May a book by University of Illinois political science professor Jason Pierceson, a leading scholar on LGBTQ issues.Pierceson’s book is called “Before Bostock: The...
Title IX Beyond Sports, 50 Years Later: Rutgers Experts Discuss Impact – Newswise
Title IX Beyond Sports, 50 Years Later: Rutgers Scholars Available to Discuss ImpactRutgers experts can discuss the significance of Title IX in their fields across a wide range of topics and...
Peter Scott-Morgan obituary | Register – The Times
One day in late 2016 Peter Scott- Morgan, an internationally renowned scientist and management consultant with a PhD in robotics, noticed he could not wiggle his toes, at least not when...
‘Respect is due’ – Wellington Advertiser
Dear Editor:
RE: Rainbow criticism, June 9.
I am a defender of free speech and freedom of faith, but when I read a letter like the one published last week from Diane...
Why Pride Month Matters To Science – Contract Pharma
June is Pride Month. The movement works to achieve equal civil rights and opportunities for LGBTQ+ individuals and encourages important conversations within science. For while LGBTQ+ people have always contributed...
‘Lightyear’ stars Chris Evans, Uzo Aduba address ‘overdue’ queer kiss – USA TODAY
In the new Pixar animated film “Lightyear,” space ranger Buzz Lightyear works through a lot of character issues, though having his best friend’s back isn’t one of them: He not only...
Men On Men Gay Art Prize Founder, Marriage Equality Activist, Gay Singer In Queen’s...
Beccy Cole. Image: Facebook
The Queen’s Birthday Honours list this year recognised the contributions of several LGBTQI community members including historian and marriage equality activist Dr Shirleene Robinson, Men on...
Biden signs executive order to counter ‘legislative attacks’ on LGBTQ rights – WJCL News...
President Joe Biden issued an executive order Wednesday to stymie what his administration calls discriminatory legislative attacks on the LGBTQ community by Republican-controlled states, declaring before a signing ceremony packed...
First public statue of female scientist in Italy celebrates astronomer – Nature.com
Margherita Hack (pictured in 2012) is depicted in a statue unveiled on 13 June in Milan.Credit: Left, Nick Zonna/ipa-agency/Shutterstock; right, Massimo Sestini/Mondadori via Getty...
India’s lingering homophobia – The Hindu
The homophobic attitude of society goes against the constitutional tenet of fraternity
The homophobic attitude of society goes against the constitutional tenet of fraternity
Pride Month comes and goes, but homophobia in India...
GOP bill seeks to eliminate ‘no-fly zones’ over Disney theme parks – Los Angeles...
A new House bill seeks to revoke federally authorized “no-fly zones” over Walt Disney Co. theme parks in the United States, including Disneyland in Anaheim. Rep. Troy Nehls (R-Texas) introduced the...
Wisconsin governor candidate Tim Michels opposes same-sex marriage – Milwaukee Journal Sentinel
MADISON – Republican governor candidate Tim Michels says he believes marriage should be between a man and a woman — a position he holds today that matches one he took two...
USask history professor honoured for contributions to Saskatoon’s 2SLGBTQ+ community – USask News
In an interview, the College of Arts and Science asked Smith about the award, her volunteer work with OUTSaskatoon and about Pride Month, which is being celebrated in...
Congratulations to the Emmaus High School Class of 2022 – East Penn School District
On June 12, 2022, the Emmaus High School Class of 2022 walked across the stage at the PPL Center to receive their diplomas. This graduation ceremony at the PPL Center is...
Chemical-free food safety – food in canada
A Canadian dairy co-operative has teamed up with Agriculture and Agri-Food Canada to develop a chemical-free way to prevent the risk of Listeria in food processing environments.
Listeria monocytogenes is one of...
Must-read LGBTQ China books for Pride Month – SupChina
LGBTQ China Books – SupChina...
I Was Bullied a Lot as a Child. Then Mentors Opened Up a New...
Elisa Vega-Burns, E87, grew up on welfare in a housing project in Brockton, Massachusetts. A path of “angels” pushed her life in an extraordinary direction. The first in her family to...
LGBTQI+ people: Making history throughout history – US Embassy in Luxembourg
Members of the LGBTQI+ community in the United States and around the world have established an impressive legacy in art, history, literature, math, science and politics.
Over the years, LGBTQI+ figures took...
LGBTQI+ people: Making history throughout history – US Embassy & Consulates in Italy –...
LGBTQI+ history makers include, clockwise from top left: Harvey Milk, Jennifer Higdon, Edith Windsor and Frank Kameny. (© Bettmann/Getty Images; © Sabina Louise Pierce/The New York Times/Redux; © Richard Drew/AP Images;...
Sikh mum still hasn’t found out how son died 25 years after body was...
A Sikh mum has been campaigning for justice for 25 years following the death of her son. Ricky Reel's body was found in the River Thames after he and...
Anti-LGBTQ Rhetoric Could Galvanize Extremists, Experts Say – Voice of America – VOA News
Boise, Idaho —
As hate speech targeting LGBTQ people increases among some far-right influencers and others online, experts are warning that extremist groups may see the rhetoric as a call to action.
Such...
Jesse M. Ehrenfeld, MD, MPH, wins office of AMA president-elect – American Medical Association
Jesse M. Ehrenfeld, MD, MPH, an anesthesiologist in Wisconsin, was voted president-elect of the American Medical Association by the physicians and medical students gathered at the 2022 AMA Annual Meeting of...
Why we need to say “gay” – Daily Californian
In comparison to other states, California is one of the most progressive when it comes to protecting LGBTQIA+ individuals and their rights. However, the fight for equality is far from over....
On the Hidden History of Gay Washington – Literary Hub
Hosted by Andrew Keen, Keen On features conversations with some of the world’s leading thinkers and writers about the economic, political, and technological issues being discussed in the news, right now.In...
Guardians of the Galaxy 3 adds Crazy Rich Asians star – The Digital Fix
The cast of Guardians of the Galaxy Vol 3 has expanded once again. Deadline reports that Nico Santos, of Crazy Rich Asians and TV series Superstore fame, has joined the MCU...
“Ōoku”: Yoshinaga Fumi’s Alternative History of a Japan Run by Women – Nippon.com
In the manga Ōoku, Yoshinaga Fumi imagines a world in which women rule Japan after most of the country’s men die from disease. The alternative version of the Edo period...